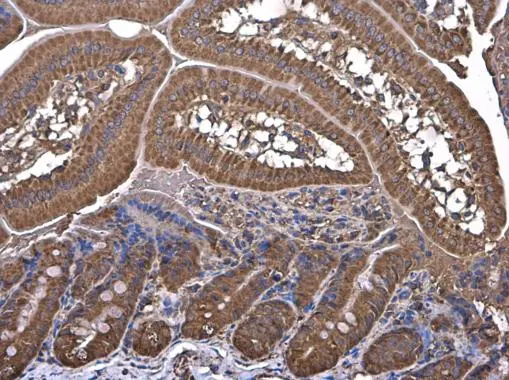
HKDC1 antibody detects HKDC1 protein at cytoplasm in mouse duodenum by immunohistochemical analysis. Sample: Paraffin-embedded mouse duodenum. HKDC1 antibody (GTX111506) diluted at 1:500.
Antigen Retrieval: Citrate buffer, pH 6.0, 15 min

Anti-HKDC1 Antibody
ER1803-32
ApplicationsFlow Cytometry, ImmunoFluorescence, Western Blot, ImmunoHistoChemistry
Product group Antibodies
ReactivityHuman, Mouse, Rat
Overview
- SupplierHUABIO
- Product NameAnti-HKDC1 Antibody
- Delivery Days Customer7
- ApplicationsFlow Cytometry, ImmunoFluorescence, Western Blot, ImmunoHistoChemistry
- Applications SupplierWB,IF-Cell,IHC-P,FC
- CertificationResearch Use Only
- ClonalityPolyclonal
- Concentration1 mg/mL.
- HostRabbit
- IsotypeIgG
- ReactivityHuman, Mouse, Rat
- Reactivity SupplierHuman,Mouse,Rat
- Storage InstructionStore at +4℃ after thawing. Aliquot store at -20℃. Avoid repeated freeze / thaw cycles.
- UNSPSC12352203